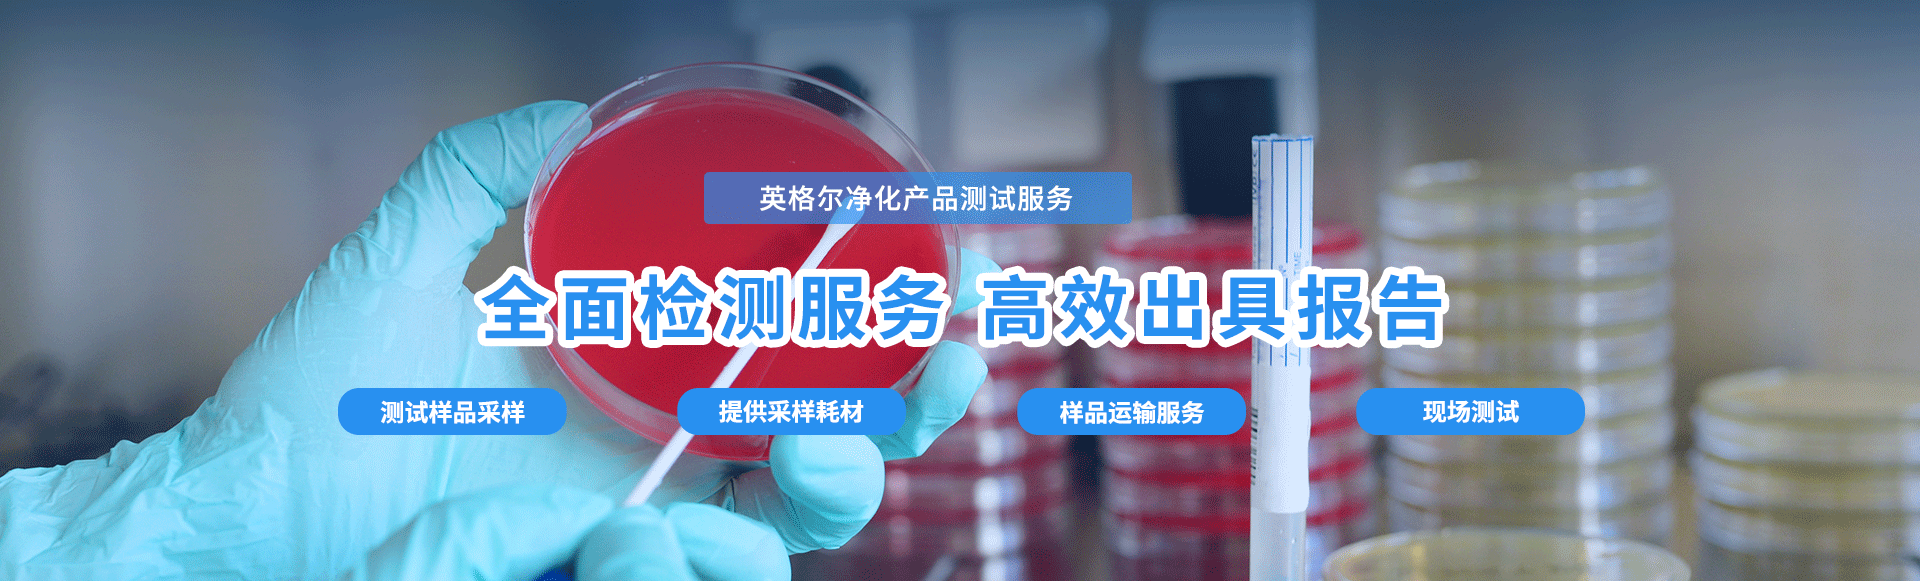

我们为净化产品产业提供
一站式技术服务
净化产品检测范围
专业为客户提供一站式服务
-
光触媒除醛剂
脱硫脱硝产品
尾气净化产品
生物除臭剂
植物除臭剂
化学除臭剂
除味剂
垃圾除臭剂
-
微生物菌剂
增氧底改剂
生物降解剂
净水复合菌
生物净水剂
杀菌灭藻剂
COD去除剂
-
净化产品检测项目
专业为客户提供一站式服务
-
净化效果测试
脱硫脱硝效果测试、尾气净化效果测试、甲醛去除率、甲苯去除率、二甲苯去除率、TVOC去除率、氨气去除率、硫化氢去除率、甲硫醇去除率、甲硫醚去除率、光合细菌、枯草芽孢杆菌、乳酸菌、酵母菌、放线菌
-
净化效果测试
重金属(铅、汞、砷)、皮肤致敏试验、鱼类毒理实验、藻类生长抑制试验、大型藻类毒理实验、蚯蚓急性毒性试验、急性经口毒性试验、急性经皮毒性试验、急性吸入毒性试验、急性眼刺激性试验、急性皮肤刺激试验
-
杀灭效果测试
杀(抑)菌、大肠杆菌、白色念珠菌、金黄色葡萄球菌、铜绿假单胞菌
-
相容性测试
铜腐蚀、不锈钢腐蚀、铝腐蚀、碳钢腐蚀、其他材料的影响
过滤材料和设备检测范围
专业为客户提供一站式服务
-
空气净化器
臭氧发生器
加湿过滤
吸尘器过滤
冰箱过滤器
除油烟机过滤
空调滤网
净水器滤芯
净水器整机
净水器配件
办公设备过滤
-
漆雾分离器
过滤棉
板滤
凝聚反装预过滤器
袋式过滤器
化学过滤
高温过滤器
燃气轮机滤筒
空气过滤器配件
空气污染控制过滤组件
中效、高效和超高效(EPA, HEPA 和 ULPA)过滤器
-
汽车空调滤清器
汽车发动机滤清器
燃料电池加湿器
过滤材料和设备检测项目
为每一位客户定制专有服务方案
- 多次通过
- 孔径
- 过滤原始效率
- 流阻
- 透气度
- 结构完整性
- 流动疲劳
- 抗破裂
- 端向载荷
- 气密性试验
- 相容性试验
- 滤芯洁净度验证
一站式服务——针对您的实际情况解决问题
为每一位客户定制专有服务方案
-
前期咨询客服针对您的情况安排相关专业人员洽谈项目细节,提供初步服务方案
-
专员服务安排专业人员安排完整的分析测试解决方案
-
专业分析专业实验人员进行实验分析,得出数据,解决生产问题
-
售后客服售后客服接洽,解答服务后产生的其他问题
专业一站式服务分析检测服务
专业为客户提供一站式服务
-
专业态度具备CMA
CNAS等多项国内外资质 -
实验严谨高新实验设备
专业团队多年经验 -
专精服务一站式服务
整体解决方案 -
经验充足服务多家企业
检验经验丰富
服务流程
为每一位客户定制专有服务方案
关于我们
打造一流客户服务体验
-
ICAS英格尔自2000年创立以来,切实把握国家战略需要、着眼行业痛点,构建“国家+企业双轮驱动”的业务战略格局,在质量保证、清洁能源、创新研发、市场服务、企业服务和战略合作等领域多元化发展,突破行业业务模式,打造开放式创新赋能平台。
未来,ICAS英格尔将继续坚持需求驱动发展,创新铸就未来,打造一流的客户服务体验,让每一位客户实现“加速业务成长,提升核心竞争力,共创可持续发展”。